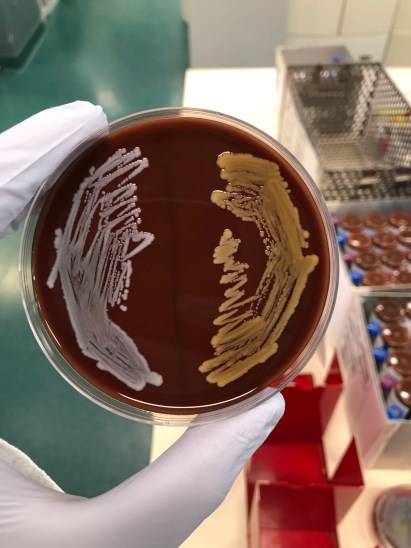
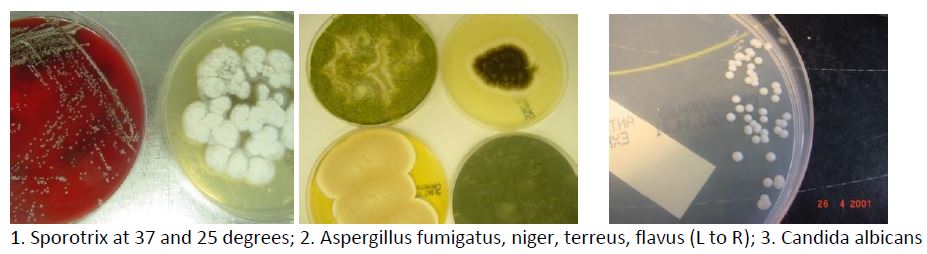

Here is excellent straightforward WHO guidance required to set up a cost-effective production facility within an LMIC hospital. Commercial product will usually cost 5-10 times the price.
Hand hygiene by staff before and after every patient interaction is one of the key ways in which to save lives from hospital acquired infection. If you need to know more, read about Ignaz Semmelweis, the father of infection control who first demonstrated that disinfecting hands saved lives in 1840s Vienna or see one of the references below.
References
- Evidence for Hand Hygiene Guidelines (WHO)
-
We need to win hearts and minds to improve hand hygiene practice: Jon Otter blog posting 2019
Image credit : Donskey et al, NEJM. Hand contaminated with MRSA after examining an abdomen (A), and after use of ABHR (B).